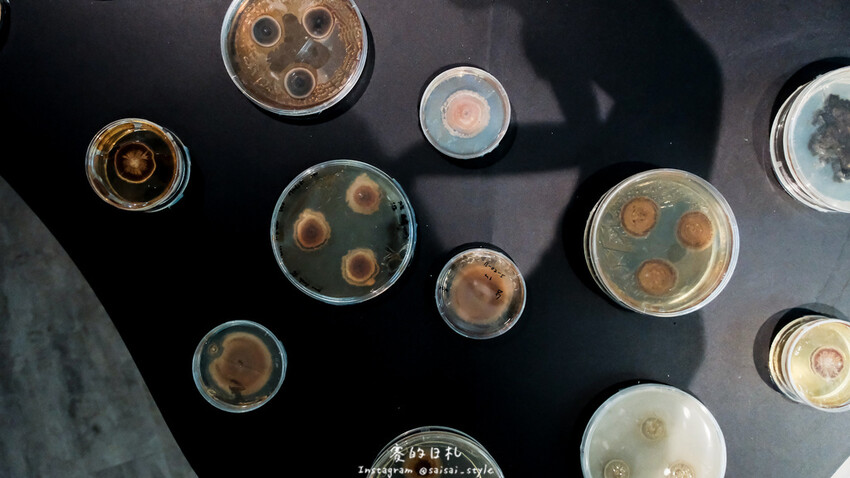
台中市霧峰區霧峰菇類產學館｜台中霧峰一日遊｜霧峰除了林家花園、光復新村外，一定也要來這間「台灣首座菇類博物館」！

今天要來跟大家好好介紹一下,這間台灣首座菇類博物館——霧峰菇類產學館,除了可以來這邊了解更多菇類的傳奇之外,4樓的地方也有霧峰農會推薦的霧峰必買的美食伴手禮。
當然都來到霧峰了,怎麼可以不去附近的一些景點走走,像是美食滿滿的樹仁商圈、文藝小店很多的光復新村、或是台灣遺址林家花園,都是台中霧峰景點推薦之一,今天就一起來場霧峰打卡景點吧!
霧峰菇類產學館 門票這裡買:
霧峰菇類產學館 霧峰區農會
台中市霧峰區四德路10號6樓(霧峰區農會)
週一休館 週二~週日 09:00~16:30
說真的,大學四年都在霧峰讀書的我,知道霧峰有很多特別景點跟美食,但霧峰菇類產學館是我第一次了解,真的是超級不好意思,但也還好我現在知道可以推薦給大家!
霧峰區農會黃景建總幹事也在2022年努力規劃與爭取下,得到行政院農業委員會及台中市政府的大力支持,並結合農試所、中興大學、亞洲大學、朝陽大學、科博館、台灣菇類專家學者及台灣菇類產業業者等眾人協助下,將該館重新改造並賦予其菇類產業教學之功能,重新命名為【霧峰菇類產學館】。
霧峰菇類產學館位於霧峰農會的6樓,一進來就看到一顆超大的香菇,兒子看到的時候直接發出了「哇~」的聲音,超級可愛。
這個超大的香菇背面,有著超多的香菇小知識,像是香菇的繁殖是靠著孢子去傳播,通常在箘蓋底下等等,這邊都可以了解到。
而每一種的菇菇都有著自己的獨特生活方式,像是腐生、共生以及寄生。
這邊挑一個比較特別的來跟大家說說好了,冬蟲夏草大家都知道,我自己一直以來其實都不太知道它到底是草還是蟲,以前還以為只是長得像蟲的菇類,結果那天才真的見識到跟了解到,主要為蟲類吃到了這種菇類的孢子,並且在蟲類的身體裡面慢慢的成長、進而控制住宿主的身體跟迴路,最後會在夏天的時候從頭的部分突出成為了菇,是不是很驚人!
我自己之前也看到過網路上的資料,但還是沒有那麼了解,今天聽到解說才真的有「哇」的感覺。
而在大地的生活中,相信著每種萬億都有著自己的聲音,霧峰菇類產學館做出了相對應的科技模式,將我們的夾子夾上每一種不同的生物,像是草、或是菇等,都會有著不同的植物聲波出現,其實、植物們在大地中也有著自己的溝通音頻,在這邊聽著他們發出的聲響,也非常的舒服、療癒。
以台灣為例,每個不同的緯度、山形的高度,都有著不同的菇類存在著,而我們可能一生都很難爬到那個高度,霧峰菇類產學館將不同緯度的菇類復刻下來,在這邊展示給眾人觀賞。
也可以看到,每一種不同的高度,產出的菇類都不同,我自己是覺得、越高山的看起來顏色越鮮豔、也看起來越毒(笑)
霧峰菇類產學館在裡頭也有一個區域,專門是辦活動的地方,這個地方通常假日比較會有活動,沒有活動的時候電視牆會播放一些菇類的縮時攝影。
在這區的後面更有著不同的特殊菇類,這種菇類會在夜晚發出淡淡的螢光光芒,像極了螢火蟲一樣,超級可愛。
在台灣使用菇類的場合跟飲食有很多,但不了解在以前的社會中、或是國外是否也是一樣,這邊也有寫出在國外的文獻、或是紀錄圖畫中,也有出現許多菇類的身影。
不只是在中國或是台灣的文學中看得到,現今中外的內容都可以了解到,菇類在生活中也是不可或缺的一部分。
而大家可能都不知道,菇類的產業中霧峰佔了很大的一塊,以台灣來說像是金針菇﹑杏鮑菇霧峰可以說是佔了很高的比例,是一個非常重要的產地。
這邊也可以看到菇類不同的產出型態,有從堆土式栽種的方式,或是使用大家比較熟知的真空包,這邊都看得到。
而菇類的生產方式也有許多,除了我剛剛說的最傳統的模式跟太空包之外,也有機械式、工廠化智能生產、或是園藝類型的種植方式,這邊也可以看到跟著時光的演變,太空包也從最原始的方式改良到變成現在這樣,更方便、也更有成效。
除了一般的食用菇類、毒性滿滿的、當然也有保健的,這邊也可以看到超厲害的牛樟芝,以及營養滿滿的「黃金蟲草」。
除了這些之外,也可以透過霧峰產學館內的設計,看到他們是如何研究菇類。以及菇類在顯微鏡下的一切。
要離開前我們也看了這邊的一些展品,都是菇類能做出來的藝術品,以及展示的菇菇產品,這邊都有很多,當然想要購買的人也可以問一下工作人員~
離開前也推薦大家可以到霧峰農會四樓的台灣農漁業物產館,裡頭有許多台灣在地優質菇類產品、其他農產品、部分文創品及生活應用商品可以選購唷!
去完了霧峰菇類產學館後,一定要帶兒子來光復新村這個網美行程,裡面有超多不同的店家、文藝小店到咖啡廳都有,這邊很適合來走走逛逛。
這個西瓜冰也是超好吃,不會過甜也很解渴!
離開霧峰之前,又回到了美食一條街的「樹仁商圈」吃我大學的回憶——老牌羊肉。
他們家的羊肉吃起來不羶,而且調味上也不會太鹹,所以吃起來也很適合小孩,而且在難停車的樹仁商圈還有自己的停車場,這樣的店家怎麼能不去呢(笑)
最後,一定要說說霧峰菇類產學館,我自己很喜歡的部分是了解菇類是怎麼樣的寄生方式,以及菇類的種類跟繁殖方式都不一樣,這點是真的蠻顛覆我的想像。
以往的概念就是菇類只會在潮濕、陰暗的地方,沒想過有哪些方式,而且環境真的很舒適之外,也有導覽可以聽,建議大家可以挑選有導覽的時間來唷!
霧峰菇類產學館 門票這裡買:
霧峰菇類產學館 霧峰區農會
台中市霧峰區四德路10號6樓(霧峰區農會)
週一休館 週二~週日 09:00~16:30